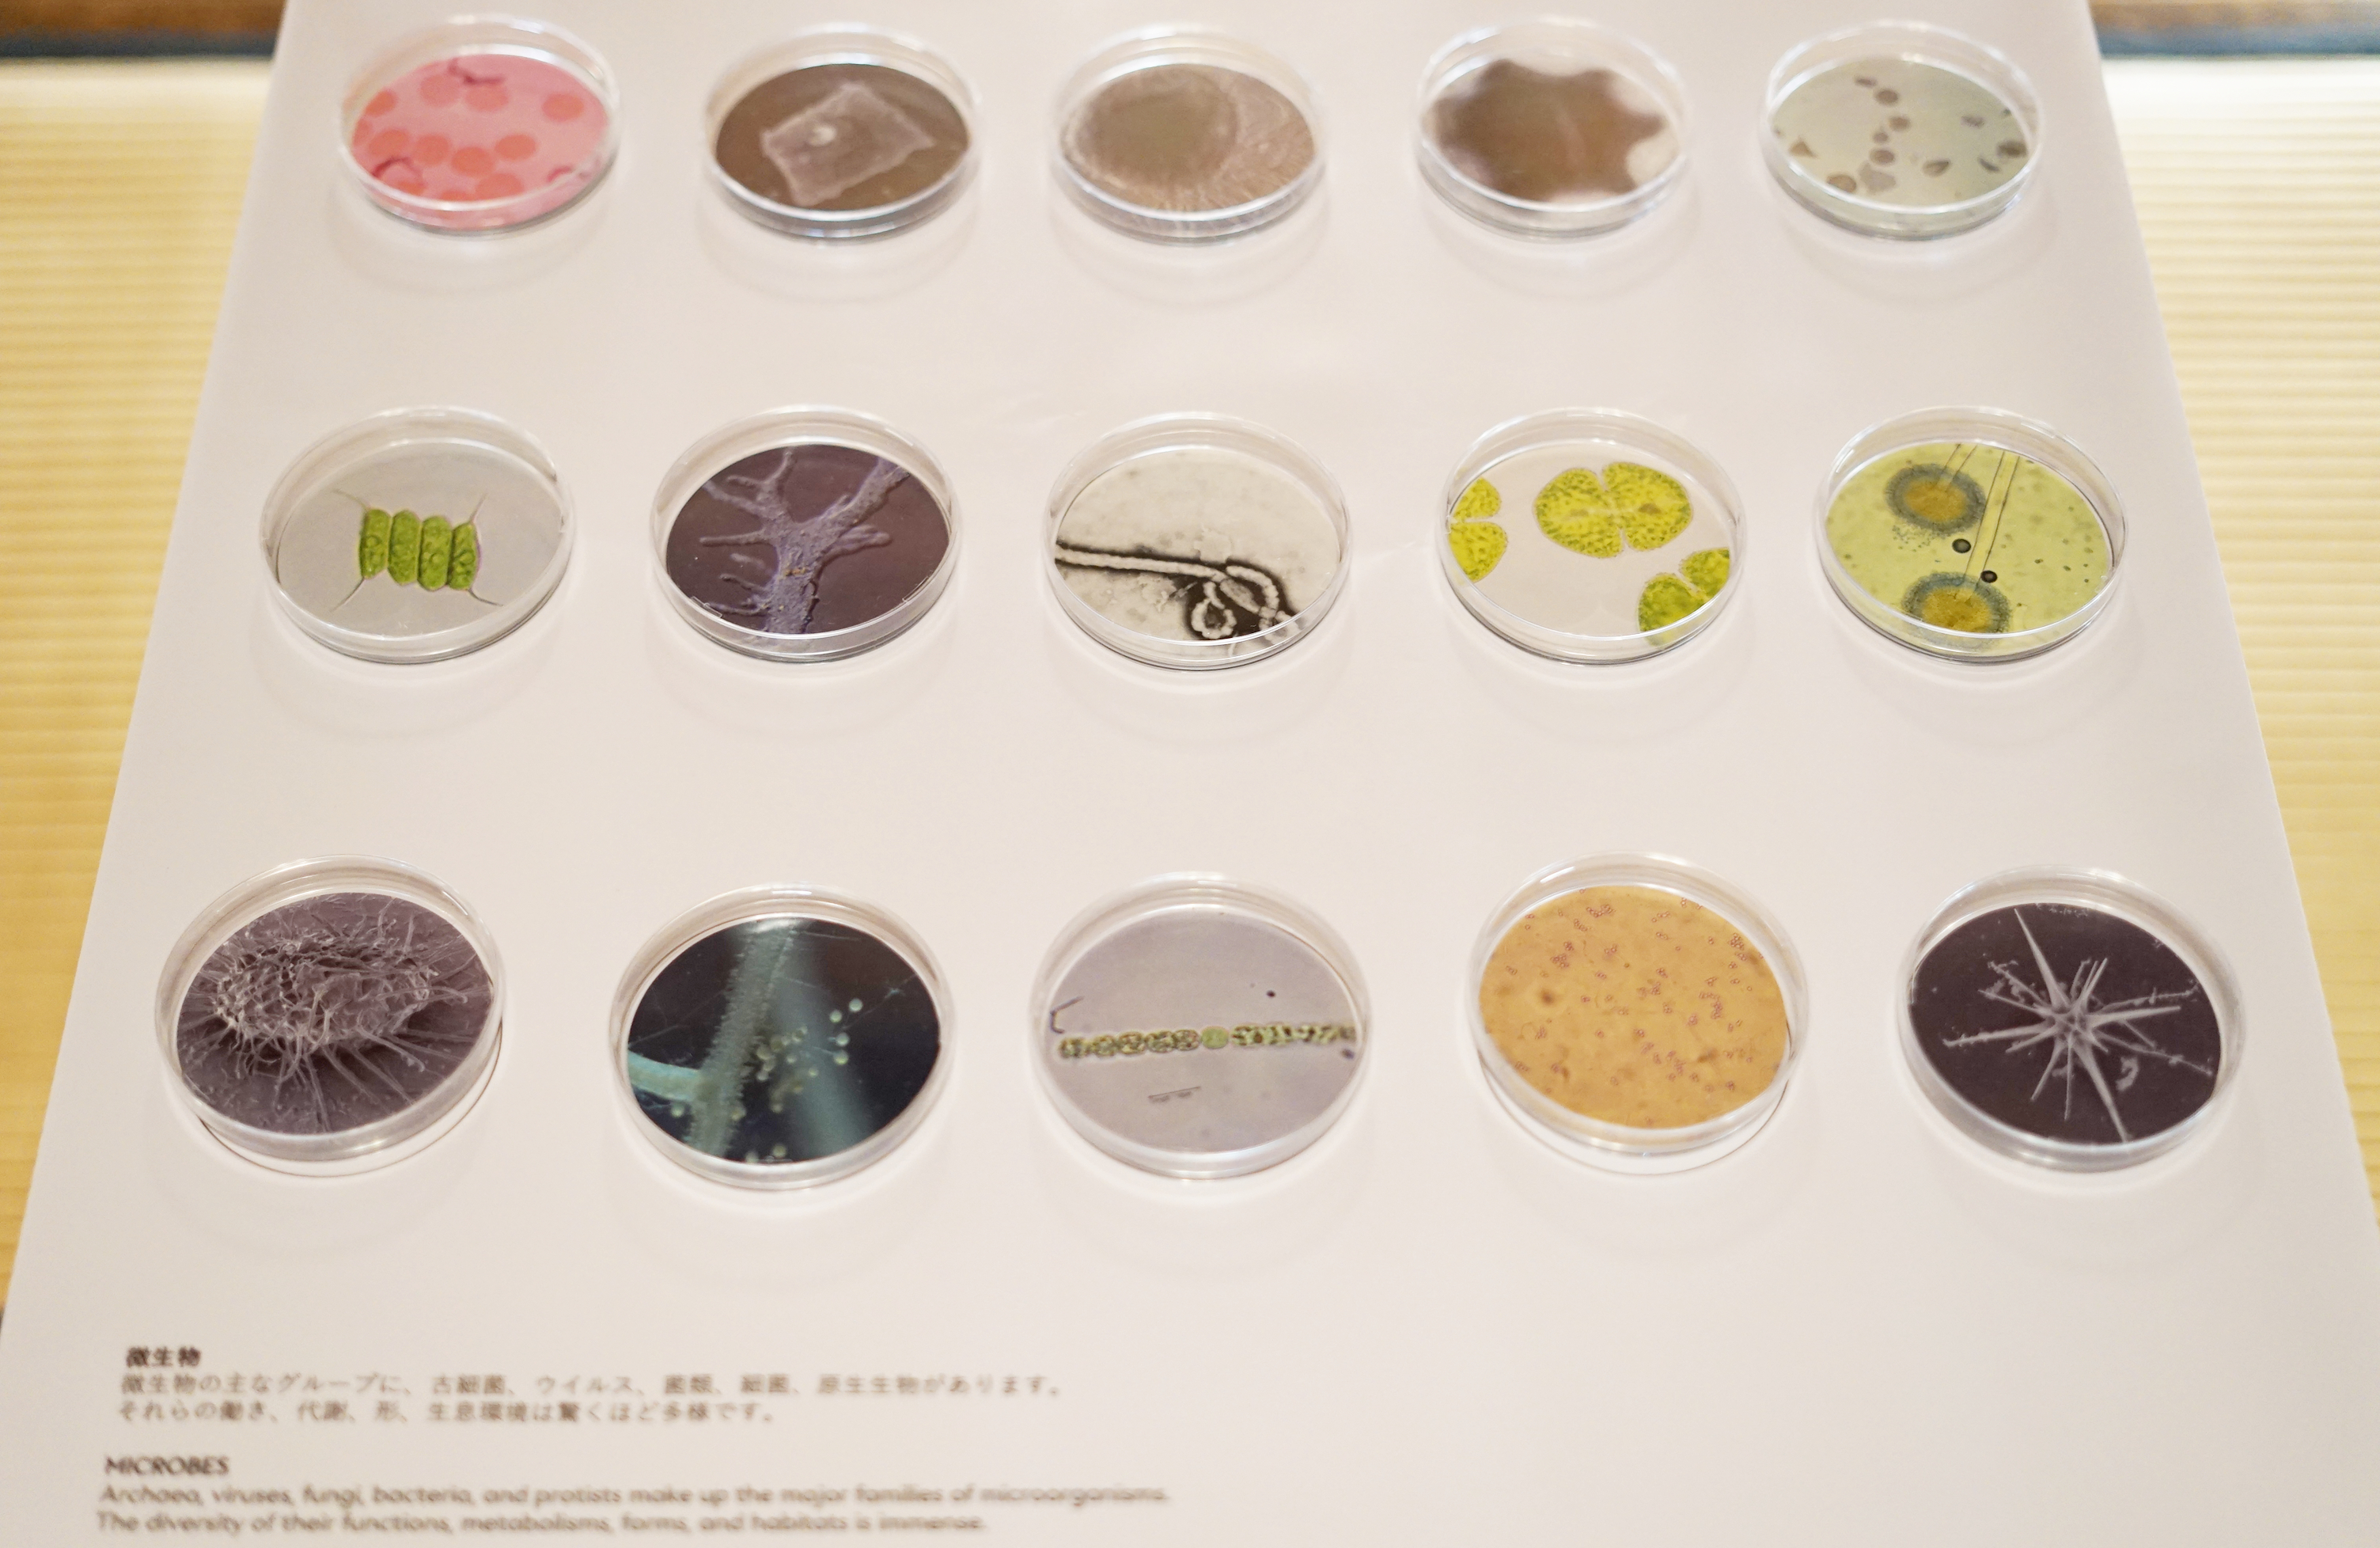

戸定邸エリアを中心に、国際連携プログラムやワークショップを開催。新エリア松戸中央公園も登場

10月24日(金)から26日(日)までの3日間、千葉県松戸市の〈戸定邸・松雲亭・戸定が丘歴史公園〉をメイン会場に、国際フェスティバル『科学と芸術の丘 2025』を開催します。今年のテーマは「Delta of Creativity − 創造のΔ −」。科学・芸術・自然という異なる流れが交わり、新たな問いや表現が芽吹く“創造の場”として、世界の最前線の知と表現が松戸に集います。
今年は、在日スイス大使館・科学技術部やオーストリア文化フォーラムとの新たな国際連携が実現。さらに、メディアアートの世界的文化機関〈アルスエレクトロニカ〉との共同キュレーションによるエキシビジョンを中心に、トーク・ワークショップを展開します。
戸定邸エリアでは、科学・芸術・自然を横断する多彩な展示が来場者を迎えます。《在日スイス大使館・科学技術部×科学と芸術の丘 MISAF Lab 共同プロジェクト》では、微生物の世界を起点に、国境を越えたシチズンサイエンスとアートの実践を紹介。生命の多様性と人間の暮らしの関係を探ります。
オーストリア文化フォーラムの協力により展示される《Floral Whispers》は、ミツバチと蜜蝋のレコードを媒介に、気候変動と記録、記憶の関係を詩的に問いかけます。さらにアルスエレクトロニカ・セレクションでは、《Synthetic Memories》《Life Ink Community》を展示し、テクノロジーと感性が交差する未来の創造性を体験可能に。加えて、《Rats in the City(都市のネズミ)》《Tabemaru》、そして《とほく おもほゆ》など、都市、環境、医療を横断する作品群が登場します。
市民・研究者・アーティストがともに「創造のΔ」をひらく3日間。その見どころをいち早くご紹介します。
公式サイト:https://science-art-matsudo.net/
アーティストコメント&見どころ
■「在日スイス大使館・科学技術部×科学と芸術の丘 MISAF Lab 共同プロジェクト」
【在日スイス大使館・科学技術部協力】

スイスと日本をつなぐ国際的なサイエンスアートプロジェクトが「科学と芸術の丘2025」に登場。2つのアプローチで“微生物の世界”を探ります。ひとつは、スイス国立研究拠点(NCCRマイクロバイオーム)とスイス・ローザンヌに所在するミュゼ・ド・ラ・マンが共同で企画した展覧会「INVISIBLES:微生物たちの隠された世界」の紹介。生命の進化から人体、環境、土壌、植物まで、微生物が担う多様な役割を伝えます。
もうひとつは、両国から約300名の市民が参加する研究「The Garden Experiment」。自宅の庭や畑で土壌サンプルを育て、微生物の多様性の変化を観察・解析する実験です。成果は来年のフェスティバルでの公開を予定しています。こうした活動を通じて、「微生物が地球や人体の健康、多様性をどう支えているのか、そして身の回りの環境はどうなっているのか」を問いかけます。
■Anca Benera & Arnold Estefán in collaboration with Pavel Brăila《Floral Whispers》
【オーストリア文化フォーラム協力】※Imagine Climate Dignity受賞作品

気候変動によって失われつつある自然の記録を試みる《Floral Whispers》。ウィーンを拠点に活動するAnca Benera & Arnold Estefán とベルリンを拠点とするPavel Brăilaによるプロジェクトで、ヨーロッパ各地を巡り、絶滅の危機にある植物の花粉を採取・アーカイブしています。
展示では、花粉の色彩をもとにしたカラーサンプルと、ミツバチが花に触れる際の振動音に着目して作られたという、蜜蝋レコードに刻んだサウンドピースを紹介。蜜蝋は再生のたびに削られ、やがて音が消えていくという仕組みです。失われゆく生命や環境の記憶を、科学と詩のあわいで静かに可視化する試みとなっています。
■Domestic Data Streamers《Synthetic Memories》
【アルスエレクトロニカ・セレクション】※Ars Electronica Award for Digital Humanity / S+T+ARTS Prize Honorary Mention 2025年ダブル受賞作品

AI技術を活用し、失われた記憶を再構築するプロジェクト《Synthetic Memories》。インタビューと生成AIを組み合わせ、参加者の記憶をイメージとして蘇らせます。記憶は精密な写真ではなく、感情や印象をともなう曖昧な像として再構成されるのが特徴。
Natalia SantolariaとAirí Dordas(共にDomestic Data Streamers)は「現実を再現するのではなく、心の中に残る主観的な記憶を蘇らせたい」と語ります。災害や戦争、強制移住、文化的タブーなどで失われた記憶を、対話を通じて拾い上げ生成画像として形にするこのプロジェクトは、認知症のセラピーや公共サービスへの応用も進行中。テクノロジーと感情の交差点で、“記憶”という人間だけが持つデータの力と意味を静かに見つめ直します。

■Ars Electronica Futurelab、ワコム、TOA《Life Ink Community》
【アルスエレクトロニカ・セレクション】

身体そのものを“ペン”として創造性を描き出す《Life Ink Community》。 Ars Electronica Futurelabとワコム、TOAが共同開発したプロジェクトです。装着したバイオセンサーが脳波・筋電・発汗などの身体信号を感知し、空間にデジタルインクのストロークとして可視化します。
チームの一人である清水陽子(科学と芸術の丘 共同創設者・グローバルアドバイザー)は、「ペンを持てない人でも、自分の創造性を“描ける”仕組みになっている」と話します。サウンドも連動し、身体の反応とともに音が響く構造は、障害のある人々との共同制作にも広がっています。今回の展示では、インタラクションによって作品が変化する仕掛けを2人同時に体験することができます。テクノロジーと感性が交差する“創造の言語”を、来場者も自らの身体で体感することができます。

■東京大学DLX Design Lab、東京大学獣医動物行動学研究室、原啓義《Rats in the City(都市のネズミ)》

都市の片隅を駆け抜ける「ネズミ」たち。その存在を、科学とデザイン、そして写真の力で見つめ直すのが本展示《Rats in the City(都市のネズミ)》です。東京大学DLX Design Lab、獣医動物行動学研究室、写真家・原の三者が協働し、都市生態系に生きるネズミの実像を多角的に探ります。
会場では、ネズミの“安寧フェロモン”と“警戒フェロモン”の香りを体験できる展示や、巣を3Dスキャンした実寸大模型、写真作品を通じて、ネズミと都市の関係を立体的に提示。「ネズミは単なる駆除対象ではなく、都市とともに生きる存在。ネズミを通して都市を考え、人々のイメージも少しずつ変えていきたい」と語る木内笙太(東京大学DLX Design Lab)の言葉が、展示全体を表しています。
■東京大学DLX Design Lab、東京大学応用昆虫学研究室《Tabemaru》

《Tabemaru》は、食品廃棄物の循環を身近に感じられるようデザインされたフードコンポストプロジェクトです。通常のコンポストが微生物によって数週間〜数ヶ月を要するのに対し、このデバイスではアメリカミズアブの幼虫を活用し、わずか数十時間で生ごみを分解。効率的かつ持続可能な循環の仕組みを提示します。昆虫や生ごみへの嫌悪感を軽減するため、装置はテラリウムのような穏やかな外観にデザイン。
今回は「丘のマルシェ」会場に展示されることで、来場者が“食べる”という日常行為と“還す”という循環のプロセスをより直感的に体感できる構成になっています。
■三木麻郁×国立病院機構新潟病院臨床研究部医療機器イノベーション研究室 石北直之*《「とほく おもほゆ」KYOTO STEAM 国際アートコンペティション2022 制作作品》
*肩書きは2022年当時のもの

医療技術と祈りの行為を重ね合わせたインスタレーション《とほく おもほゆ》。アーティストの三木麻郁と医師・石北直之による共同制作で、3Dプリンタ製の人工呼吸器をモチーフに構成されています。コロナ禍に世界中で呼吸器不足が叫ばれる中、石北によって考案された試作機をもとに、三木が「呼吸」そのものを問い直す作品として再構築しました。
会場には18体の人工呼吸器が並び、6音ずつのハーモニーが生まれる音のインスタレーションとして展開。作品タイトルには、“遠くを自然と思わせる”という古語の意味が込められています。三木が語る「遠くを思う気持ちは太古から受け継がれてきた祈りの形」という言葉どおり、医療と芸術、そして人と人の間に流れる“いのちの呼吸”を静かに可視化する展示です。

ディレクターコメント
■岩澤哲野 共同ディレクター(社会戦略&地域連携)

科学と芸術の丘は、2018年にスタートした科学、芸術、自然をつなぐ国際フェスティバルです。メイン会場の戸定が丘を中心に、今年もまち中で多くのカタリストイベントを展開。さらに相模台にある松戸中央公園を新エリアとして立ち上げ開催します。
今年のテーマは“Delta of Creativity − 創造のΔ −”。デルタという記号が象徴するように、単一の答えではなく、狭間に生まれる問いや表現にこそ創造の豊かさがあると考えています。多様な作品が集まった今回のフェスティバルを通じて、その多層的な創造のかたちを楽しんでいただけたらと思います。
■海野林太郎 共同ディレクター (クリエイティブ・ディレクション&キュレーション)

今年のテーマ“Delta of Creativity”は、三角形の三つの点、「科学・芸術・自然」をつなぐイメージから始まりました。もともと、このフェスティバル自体も、その三つの領域を結ぶ場として立ち上がったものでもあります。
メイン会場である戸定邸の建築は、外と中の境界がとても曖昧で、風や鳥の声、自然の気配が展示空間にそのまま入り込みます。そういう空間だからこそ、テクノロジーやアート、自然といった領域を横断する作品が、より豊かに立ち上がります。記憶をめぐるセッションも、サウンドの作品も、この場所にあることで新しい見え方が生まれるのではないかと考えています。
松戸を舞台に開催される「科学と芸術の丘 2025」では、アート展示を中心に、ワークショップ、トーク、マルシェ、まちをめぐるスタンプラリーなど、多彩なプログラムが繰り広げられます。
新たに会場として加わった松戸中央公園では、アーティストによる展示のほか、現代アートを身近に感じられるワークショップやトーク、マルシェなど、創造に触れる多様な体験が展開されます。メイン会場の戸定が丘歴史公園では、クリエイティブなショップやカフェが集う「丘のマルシェ」を開催し、松戸ならではの文化と人の交流を育みます。
そして松戸市内各所にて、開催テーマである「Δ」から着想を得た商品、サービス、作品の展示・販売を行う「カタリストイベント」も展開。
「科学と芸術の丘」は、市民が中心となって企画・運営する国際フェスティバルです。科学と芸術、日常と創造をつなぎながら、多様な人々の関わりが新たな表現を生み出す。松戸のまち全体が、”創造の芽吹く場”となる3日間に、ぜひご参加ください。
《Information》
科学と芸術の丘2025
会期:2025年10月24日(金) / 25日(土) 10:00 〜 16:30 、26日(日) 10:00 〜 16:00
会場:千葉県松戸市(戸定邸、松雲亭、戸定が丘歴史公園、松戸市内各所)
料金:一般 1,000円、高校生・大学生 900円、松戸市市民割 500円(在住/在勤/在学の方)、中学生以下 無料
*一般、高校生・大学生の当日券は500円増し
*トーク、ワークショップなどへの参加は別途予約が必要です。
主催:松戸市、科学と芸術の丘実行委員会
企画運営:科学と芸術の丘実行委員会
パートナー:在日スイス大使館・科学技術部 、オーストリア文化フォーラム東京、NCCRマイクロバイオーム、国立研究開発法人 産業技術総合研究所 バイオものづくり研究センター 微生物システム創発研究チーム
協力:Ars Electronica(アルスエレクトロニカ)、千葉大学園芸学部 応用昆虫学野村研究室、遅四グランプリ実行委員会、あーとえきっぷ、戸定祭実行委員会、松戸アートピクニック実行委員会
プロジェクト助成:サカエ・シュトゥンツィ基金
協賛:株式会社生物技研、株式会社ビーテック、株式会社むかしの堆肥、株式会社アトレ、京葉ガス株式会社、マブチモーター株式会社、プラーレ松戸、イトーヨーカ堂 松戸店、KITE MITE MATSUDO、株式会社千葉銀行、株式会社千葉興業銀行、東京ベイ信用金庫
ツアーサポート:松戸シティガイド
後援:JOBANアートライン協議会、松戸商工会議所、一般社団法人松戸市観光協会、公益財団法人松戸市文化振興財団、公益財団法人松戸市国際交流協会、松戸市教育委員会
助成:令和7年度 文化庁 文化芸術創造拠点形成事業
